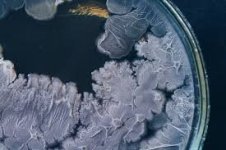
images (2).jpg

Рацион подобран правильно)Очень красивая и аккуратная!
Видимо хорошо питается!![]()
Спасибо за внимание Бро)
Смотрите видео ниже, чтобы узнать, как установить наш сайт в качестве веб-приложения на домашнем экране.
Примечание: В настоящее время эта функция требует доступа к сайту с помощью встроенного браузера Safari.
Смотрите видео ниже, чтобы узнать, как установить наш сайт в качестве веб-приложения на домашнем экране.
Примечание: В настоящее время эта функция требует доступа к сайту с помощью встроенного браузера Safari.
Добро пожаловать на форум гроверов GanjaLive – уникальное сообщество, объединяющее энтузиастов и профессионалов в сфере выращивания конопли и грибов. Здесь вы найдете бесценные советы, проверенные методы и личные истории, которыми делятся участники и со всего мира.
Наш форум создан для тех, кто стремится углубить свои знания в гроувинге и улучшить навыки в культивации. Вне зависимости от уровня опыта – будь вы новичок или эксперт – у нас всегда найдется место для обсуждений, вопросов и обмена идеями.
Мы ценим свободу слова и поддерживаем анонимность наших пользователей, обеспечивая безопасность и конфиденциальность обсуждений среди гроувинг специалистов на высоком технологичном уровне (более подробно в Политике конфиденциальности, или Дисклеймере). Форум гровинга GanjaLive – это больше, чем просто форум. Это сообщество людей 18+, объединенных общим интересом, где каждый может найти полезную информацию и поддержку на пути к совершенству в выращивании.
Присоединяйтесь к нам, делитесь опытом, учитесь новому и станьте частью динамичного и развивающегося сообщества GanjaLive!
Рацион подобран правильно)Очень красивая и аккуратная!
Видимо хорошо питается!![]()
Спасибо Браза!) Сейчас забегу к тебе в репХорошая растиха Брат)
100 пудов один в один сцуко, только маленькие :s002:звездный десант
Фигасе немного..! Репорт с последнего сообщения вверх листал, увидел кучу листвы - думал ты её ваще зарезал))))Решил немного подстричь девку)
Фигасе немного..! Репорт с последнего сообщения вверх листал, увидел кучу листвы - думал ты её ваще зарезал))))
Рано) Та да Братан, сам окуевший, и нужного эффекта не получил, этот шар сцуко вообще свет пропускать не хочетА прикинь они размером с собаку. В сад вышел, а они сидят на яблонях..100 пудов один в один сцуко, только маленькие :s002:
Тоже еще не зацвел? У меня тоже. Когда уже зацветет как думаешь. У тебя в начале ноября думаешь дозреет? У меня в начале ноября еще плюс держится где то 7~8. Как думаешь успеет отцвести индюха если еще даже предцвета нет? А растиxа у тебя огонь. У меня чуть по меньше. Bubblelicious f/f. Кто нибудь поднимал как по эффектy?
Стимулятором может быть фосфорно калийное удобрение, или начать накрывать растение черной тканью, чтоб свет не пропускала.На счет сорта понял бро. У меня тоже соотношение 20/80 sat/ind. Может надо какие нибудь симуляторы для цвета дать ей. Или сама зацветет она во время без всяких симуляторов?
Я и не надеялся что так рано зацветет) конец августа как правило.. Цветет у меня только грин пойсон и северное сияние, они ранние в этом смысле. у меня харв был в прошлом году 30 октября,почти все вызрело. 7-8 в ноябре это гуд, вызреют! Покажи свою растиху.Тоже еще не зацвел? У меня тоже. Когда уже зацветет как думаешь. У тебя в начале ноября думаешь дозреет? У меня в начале ноября еще плюс держится где то 7~8. Как думаешь успеет отцвести индюха если еще даже предцвета нет? А растиxа у тебя огонь. У меня чуть по меньше. Bubblelicious f/f. Кто нибудь поднимал как по эффектy?
Покажу бро только позже скину. Как съездию на поляну. Значит я спокоен если к концу октября вызреет.Стимулятором может быть фосфорно калийное удобрение, или начать накрывать растение черной тканью, чтоб свет не пропускала.
Я и не надеялся что так рано зацветет) конец августа как правило.. Цветет у меня только грин пойсон и северное сияние, они ранние в этом смысле. у меня харв был в прошлом году 30 октября,почти все вызрело. 7-8 в ноябре это гуд, вызреют! Покажи свою растиху.
Давай Бро давай)К концу августа надеюсь догоню твою по размеру)))
Здоров Бро! Забил я на розы, когда ухаживал были тоже огромные) Вчера дождь по всей Украине был, да и чернозема не мало у нас) так что.. А там хз, мож и соседиПривет бро!У нас тоже дождь вчера лупил с ночи и до вечера,чёт у тебя розы маленькие мои в два раза шире и выше.У тебя тоже земля чернозём,значит соседи скорее всего.Похолодало не по-детски сегодня утром +14 .
Как говорил Келп : " ты заходи если че, пароль красный глаз"))Азот уже в почве есть думаю. Потому что она заряжена уже. Там раньше куры гуляли лет 5~6. Так что с удобрением там огонь. Это я просто фосфор купил чтобы быстрее зацвела. Тороплюсь наверное)))
Если там куры гуляли как ты говоришь, то фосфор и калий там точно есть, а вот азот дело летучее(газ) сегодня есть, а завтра уже нет) Тут не думать надо, Бро, а смотреть по растениюАзот уже в почве есть думаю. Потому что она заряжена уже. Там раньше куры гуляли лет 5~6.
азот НЭТ